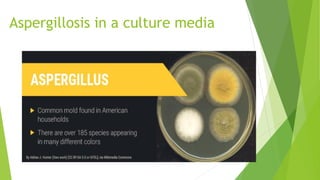
Aspergillosis in a culture media

The document provides an overview of opportunistic mycoses, highlighting the types including candidiasis, aspergillosis, zygomycosis, cryptococcosis, and pneumocystis carinii, which primarily affect immunocompromised individuals. It details the causative agents, pathogenesis, clinical manifestations, and laboratory diagnosis for each infection, emphasizing the need for accurate identification of fungi in at-risk patients. Additionally, the document discusses treatment options and preventive measures against these infections.